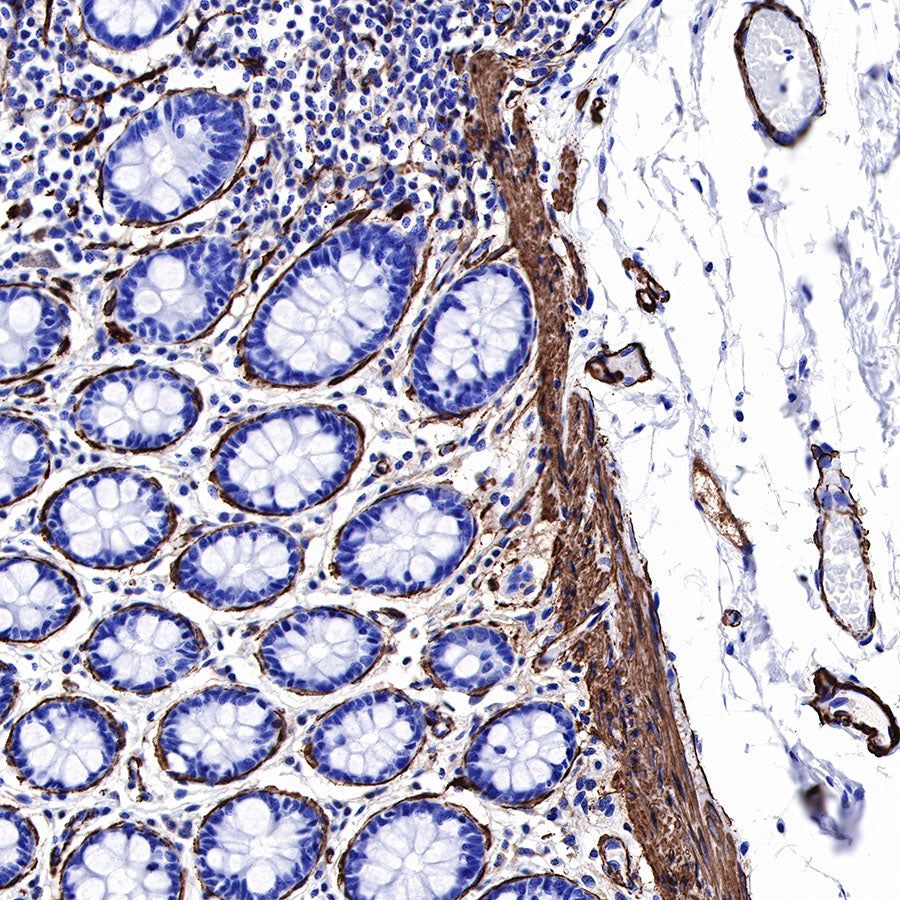
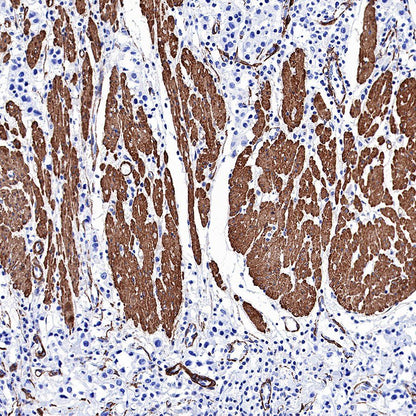
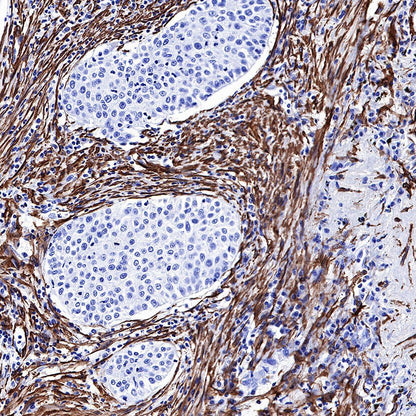

Product Details
Product Details
Product Specification
| Host | Rabbit |
| Antigen | alpha smooth muscle Actin (SMA) |
| Synonyms | Alpha-actin-2, ACTA2 |
| Immunogen | Synthetic Peptide |
| Location | Cytoplasm, Cytoskeleton |
| Accession | P62736 |
| Clone Number | SDT-132-63 |
| Antibody Type | Rabbit mAb |
| Application | WB, IHC-P, IF |
| Reactivity | Hu, Ms |
| Purification | Protein A |
| Concentration | 0.0625 mg/ml |
| Physical Appearance | Liquid |
| Storage Buffer | PBS, 40% Glycerol, 0.05%BSA, 0.03% Proclin 300 |
| Stability & Storage | 12 months from date of receipt / reconstitution, -20 °C as supplied |
Dilution
| application | dilution | species |
| IHC-P | 1:1000 | |
| IF | 1:125 | |
| WB | 1:2000-1:10000 |
Background
α-smooth muscle actin, encoded by ACTA2, is expressed in abundance in vascular smooth muscle, comprising 50–70% of total actin, with the remainder composed of β-cytoplasmic and γ-actins. Whereas Sα-smooth muscle expression is normally restricted to smooth muscle cells, it can also be expressed in nonmuscle cells, most notably myofibroblasts that use cell traction forces to remodel extracellular matrix.
Picture
Picture
Western Blot

WB result of alpha smooth muscle Actin (SMA) Rabbit mAb
Primary antibody: alpha smooth muscle Actin (SMA) Rabbit mAb at 1/6250 dilution
Lane 1: mouse skeletal muscle lysate 20 µg
Lane 2: mouse colon lysate 20 µg
Negative control: mouse skeletal muscle
Secondary antibody: Goat Anti-Rabbit IgG, (H+L), HRP conjugated at 1/10000 dilution
Predicted MW: 42 kDa
Observed MW: 42 kDa
Exposure time: 60 s
Immunohistochemistry

IHC shows positive staining in paraffin-embedded human colon. Anti-alpha smooth muscle Actin (SMA) antibody was used at 1/1000 dilution, followed by a HRP Polymer for Mouse & Rabbit IgG (ready to use). Counterstained with hematoxylin. Heat mediated antigen retrieval with Tris/EDTA buffer pH9.0 was performed before commencing with IHC staining protocol.

IHC shows positive staining in paraffin-embedded human gastric carcinoma. Anti-alpha smooth muscle Actin (SMA) antibody was used at 1/1000 dilution, followed by a HRP Polymer for Mouse & Rabbit IgG (ready to use). Counterstained with hematoxylin. Heat mediated antigen retrieval with Tris/EDTA buffer pH9.0 was performed before commencing with IHC staining protocol.

IHC shows positive staining in paraffin-embedded human cardiac muscle. Anti-alpha smooth muscle Actin (SMA) antibody was used at 1/1000 dilution, followed by a HRP Polymer for Mouse & Rabbit IgG (ready to use). Counterstained with hematoxylin. Heat mediated antigen retrieval with Tris/EDTA buffer pH9.0 was performed before commencing with IHC staining protocol.

IHC shows positive staining in paraffin-embedded human lung cancer. Anti-alpha smooth muscle Actin (SMA) antibody was used at 1/1000 dilution, followed by a HRP Polymer for Mouse & Rabbit IgG (ready to use). Counterstained with hematoxylin. Heat mediated antigen retrieval with Tris/EDTA buffer pH9.0 was performed before commencing with IHC staining protocol.

IHC shows positive staining in paraffin-embedded human prostatic hyperplasia. Anti-alpha smooth muscle Actin (SMA) antibody was used at 1/1000 dilution, followed by a HRP Polymer for Mouse & Rabbit IgG (ready to use). Counterstained with hematoxylin. Heat mediated antigen retrieval with Tris/EDTA buffer pH9.0 was performed before commencing with IHC staining protocol.

IHC shows positive staining in paraffin-embedded human skeletal muscle. Anti-alpha smooth muscle Actin (SMA) antibody was used at 1/1000 dilution, followed by a HRP Polymer for Mouse & Rabbit IgG (ready to use). Counterstained with hematoxylin. Heat mediated antigen retrieval with Tris/EDTA buffer pH9.0 was performed before commencing with IHC staining protocol.
Immunofluorescence

IF shows positive staining in paraffin-embedded mouse colon. Anti-alpha smooth muscle Actin (SMA) antibody was used at 1/125 dilution (Green) and incubated overnight at 4°C. Goat polyclonal Antibody to Rabbit IgG - H&L (Alexa Fluor® 488) was used as secondary antibody at 1/1000 dilution. Counterstained with DAPI (Blue). Heat mediated antigen retrieval with Tris/EDTA buffer pH9.0 was performed before commencing with IF staining protocol.